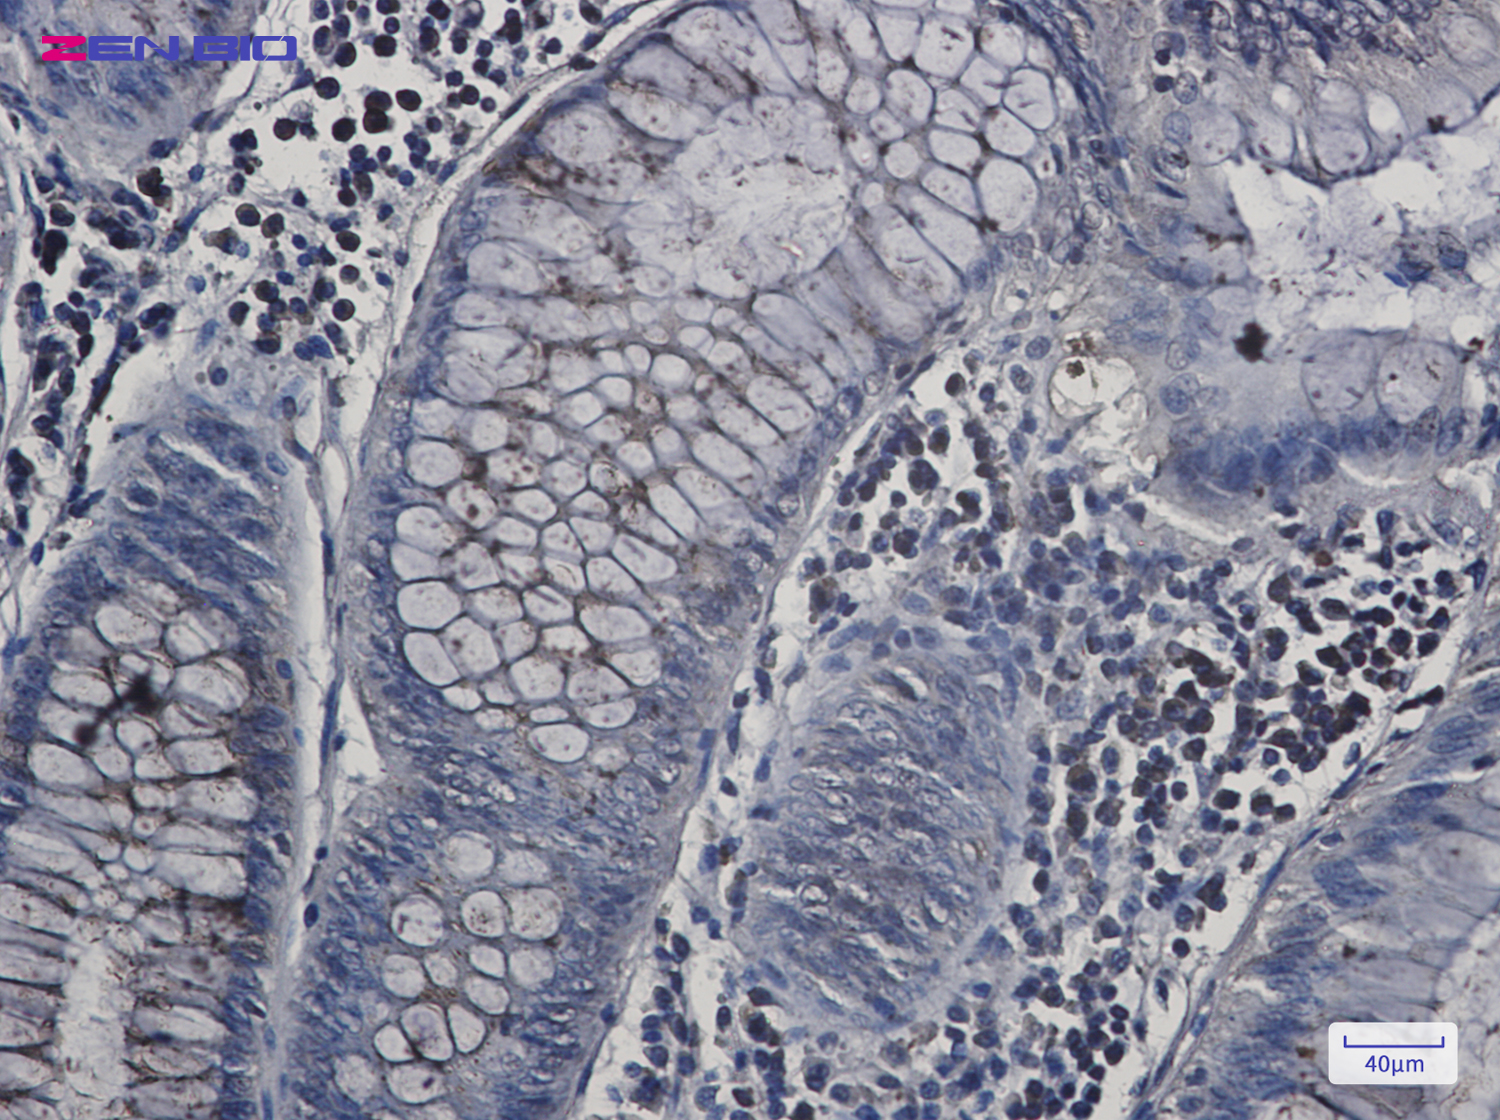

-
Product Name
Anti-N WASP Rabbit antibody
- Documents
-
Description
N WASP Rabbit polyclonal antibody
-
Tested applications
WB, IHC-P, ICC/IF, FC
-
Species reactivity
Human, Mouse
-
Alternative names
NWASP; WASPB; N-WASP antibody
-
Isotype
Rabbit IgG
-
Preparation
Antigen: A synthetic peptide of human N-WASP
-
Clonality
Polyclonal
-
Formulation
Supplied in 50nM Tris-Glycine(pH 7.4), 0.15M Nacl, 40%Glycerol, 0.01% sodium azide and 0.05% BSA.
-
Storage instructions
Store at -20°C. Stable for 12 months from date of receipt.
-
Applications
WB: 1/1000-1/2000
IHC: 1/20-1/50
ICC/IF: 1/50
FC: 1/20-1/100
-
Validations

Western blot detection of N-WASP in 3T3 cell lysates using N-WASP Rabbit pAb(1:1000 diluted).Predicted band size:55kDa.Observed band size:65kDa.
Immunohistochemistry of N-WASP in paraffin-embedded Human colon cancer tissue using N-WASP Rabbit pAb at dilution 1/20

Immunocytochemistry of N-WASP(green) in Hela cells using N-WASP Rabbit pAb at dilution 1/50, and DAPI(blue)
-
Background
Swiss-Prot Acc.O00401.Regulates actin polymerization by stimulating the actin-nucleating activity of the Arp2/3 complex (PubMed:9422512, PubMed:16767080, PubMed:19366662, PubMed:19487689, PubMed:22847007, PubMed:22921828). Involved in various processes, such as mitosis and cytokinesis, via its role in the regulation of actin polymerization (PubMed:9422512, PubMed:19366662, PubMed:19487689, PubMed:22847007, PubMed:22921828). Together with CDC42, involved in the extension and maintenance of the formation of thin, actin-rich surface projections called filopodia (PubMed:9422512). In addition to its role in the cytoplasm, also plays a role in the nucleus by regulating gene transcription, probably by promoting nuclear actin polymerization (PubMed:16767080). Binds to HSF1/HSTF1 and forms a complex on heat shock promoter elements (HSE) that negatively regulates HSP90 expression . Plays a role in dendrite spine morphogenesis .
Related Products / Services
Please note: All products are "FOR RESEARCH USE ONLY AND ARE NOT INTENDED FOR DIAGNOSTIC OR THERAPEUTIC USE"
